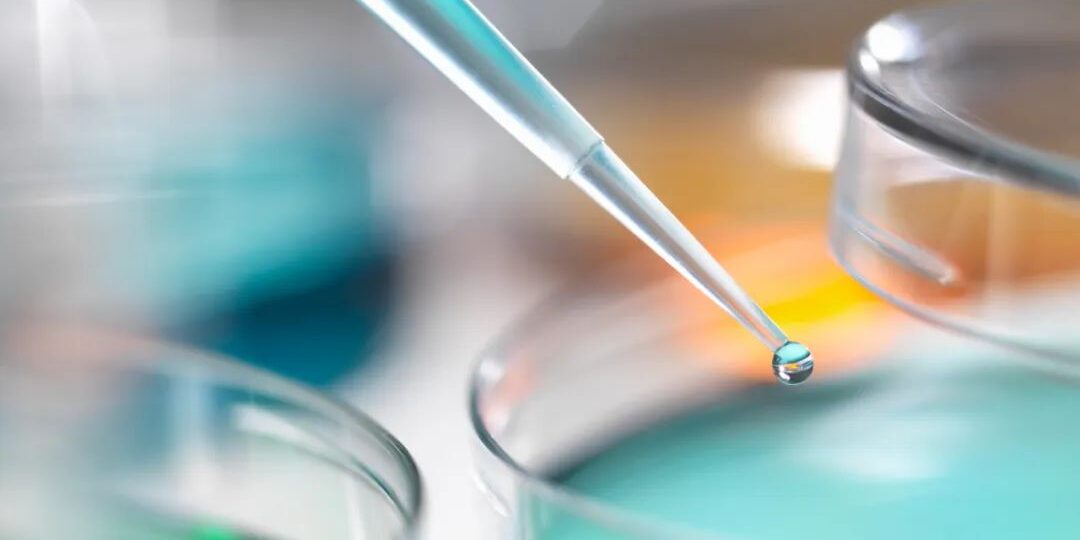

How to use industrial cleaning and defoaming agents
How to use:
Industrial cleaning defoamer can be added directly. The amount of defoamer can be 0.5‰~0.6%. The optimal amount can be adjusted by the customer according to the specific situation. Silicone, fatty alcohol, and silicone polyether type defoamer can be diluted and used. If stored for a long time, a certain concentration of thickening water needs to be used for dilution and a certain amount of preservatives need to be added; if used on site, water can be added directly for dilution. Use it in time to prevent it from deteriorating over time. The speed during the mixing process should not be too fast, just stir evenly. It is not recommended to dilute polyether and mineral oil defoaming agents.
Note:
If skin irritation occurs, seek medical attention promptly. Dispose of in accordance with local regulations. Defoaming agent is suitable for storage at 5~35℃. Do not place it near a heat source or expose it to the sun. According to general chemical storage methods, ensure sealing after use to avoid deterioration.
Product use:
Used for foaming in steel plate cleaning & beer bottle cleaning, PCB circuit boards (film stripping, etching, development), electroplating liquid & electroplating cleaning. It can adapt to the process requirements of various cleaning agents and will not cause defects such as oil spots, color spots and rust on the cleaning objects. Suitable for the defoaming and suppression needs of various cleaning industries.